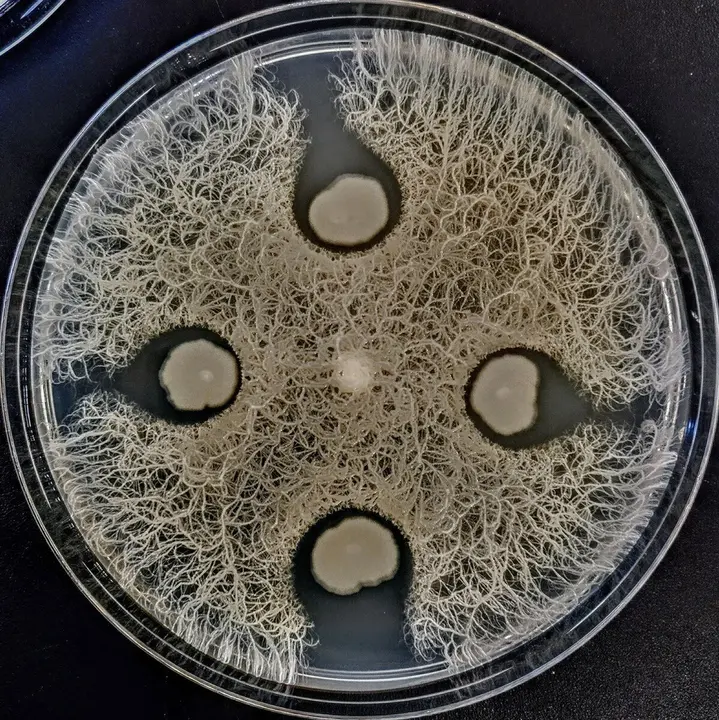

El proyecto 'Micromundo', desarrollado por la Fundación Española para la Ciencia y la Tecnología (FECYT) del Ministerio de Ciencia, Innovación y Universidades, con el respaldo de la Sociedad Española de Microbiología (SEM), la Universidad de Cantabria (UC) y el Instituto de Investigación Sanitaria Marqués de Valdecilla (IDIVAL) y en colaboración con las consejería de Sanidad y Educación del Gobierno de Cantabria, ha descubierto nuevos microorganismos en los suelos de Cantabria frente a bacterias super resistentes a antibióticos.
Los resultados de este proyecto, que tiene como objetivo aislar nuevos microorganismos productores de antibióticos, se presentarán el próximo 24 de junio en el Palacio de Festivales de Santander, según ha informado en un comunicado la Universidad de Cantabria.
'MicroMundo' es el nombre adoptado en España del proyecto de escala mundial llamado 'Small World Initiative', que nació ante la problemática actual causada por la creciente resistencia a los antibióticos. Este proyecto está basado en una estrategia de aprendizaje-servicio y ciencia ciudadana, por lo que son los estudiantes de Bachillerato junto con su profesorado quienes lideran el proyecto, lo que fomenta las vocaciones científicas en el alumnado.
Tras la formación recibida por los investigadores responsables, los 33 profesores junto con su alumnado de Bachillerato provenientes de 20 centros educativos, tomaron muestras de distintos puntos de la región y aislaron bacterias productoras de sustancias antibióticas. Para ello, IDIVAL y la Facultad de Medicina les proporcionaron a los estudiantes un 'kit' de materiales que pudieron utilizar en los laboratorios de cada centro educativo.
Ya en el IDIVAL, el IBBTEC y la Facultad de Medicina, y gracias al trabajo del personal investigador implicado, se han realizado casi 11.200 ensayos con estos microorganismos para encontrar nuevos compuestos frente a bacterias patógenas como las superbacterias multirresistentes de las especies Acinetobacter, Staphylococcus MRSA, Enterobacter, Pseudomonas o Klebsiella pneumoniae, todas ellas causantes de enfermedades graves en pacientes hospitalizados en el Hospital Marqués de Valdecilla. Por el momento, al menos 124 bacterias, tienen propiedades antimicrobianas frente a algunas de estas superbacterias.
En el congreso, y mediante formato póster, los propios estudiantes serán los que presenten los resultados obtenidos ante un jurado y se otorgarán diferentes premios en diversas categorías. Este evento, que estará abierto a la comunidad educativa y al público en general, hará especial énfasis en la necesidad de preservar los actuales antibióticos para que sean útiles el mayor tiempo posible, y en encontrar otros nuevos, porque los que tenemos están dejando de funcionar.
INVESTIGADORES A CARGO DEL PROYECTO
Félix J. Sangari García, profesor de Microbiología Médica y Parasitología de la Facultad de Medicina e investigador del grupo de Microbiología Molecular de la Patogenicidad de Brucella, adscrito al Instituto de Biomedicina y Biotecnología de Cantabria (IBBTEC), impartió la formación en la facultad el pasado mes de febrero al profesorado y ha trabajado con la colaboración de tres estudiantes de Medicina, a través de la AJIEMCA (Asociación Juvenil de Intercambio de Estudiantes de Medicina de Cantabria), en la identificación posterior de las bacterias y en los ensayos de sustancias antibióticas contra bacterias superresistentes.
Asimismo, participaron dos alumnas del programa de mentorías universitarias enfocado a alumnado de altas capacidades denominado `Amentúrate', desarrollado por el departamento de Educación de la UC.
En el IDIVAL, el equipo de investigación lo lidera el doctor José Ramos Vivas, que pertenece al grupo de Microbiología Clínica y Molecular de este instituto y que ha contado con la colaboración de la biotecnóloga María Lázaro Díez, la bióloga Itziar Chapartegui Iglesias y Natalia Calvo.
En los dos centros han participado dos alumnas en prácticas del IES Cantabria que realizan estudios de técnico de laboratorio.
CENTROS EDUCATIVOS PARTICIPANTES
Este año han participado alumnos de primero de Bachillerato de los siguientes centros: Colegio Torreánaz (Ánaz), IES José María Pereda (Santander), IES Montesclaros (Reinosa), Colegio La Salle (Santander), IES Miguel Herrero (Torrelavega), IES Lope de Vega (Cayón), IES La Granja (Heras), IES Foramontanos (Cabezón de la Sal), Colegio Esclavas (Santander), Colegio Escolapios (Santander), IES Valle de Piélagos (Renedo), IES Zapatón (Torrelavega), Colegio Castroverde (Santander), IES Las Llamas (Santander), IES Ricardo Bernardo (Solares), IES Santa Clara (Santander), IES San Miguel de Meruelo (Meruelo), IES Ataúlfo Argenta (Castro), IES Fuente Fresnedo (Laredo), Colegio San José-Niño Jesús (Reinosa) y como centro invitado, el IES Marqués de Santillana (Torrelavega).